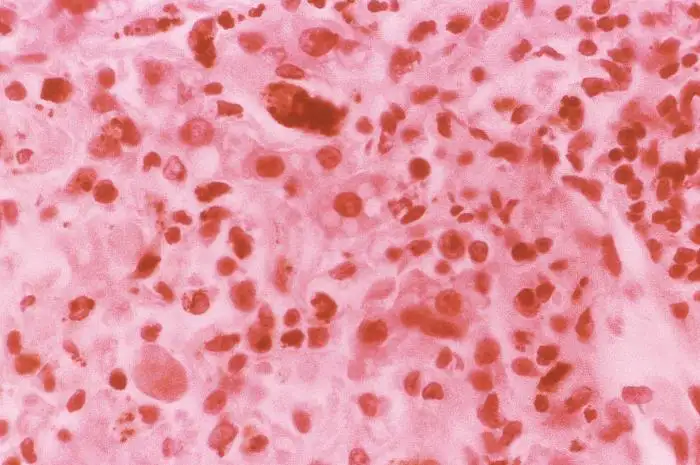
黄热病相关病理图像

1793年8月的费城,空气中弥漫着一种说不清的甜腥味。当时美国最大的城市、新生国家的临时首都,正沉浸在夏末的闷热之中。码头工人们忙碌地卸下来自加勒比海的货物,没有人注意到,死神已经悄然登岸。
第一个倒下的是一名水手,他在码头附近的住所里开始发烧、呕吐。几天后,他的眼睛变成了金黄色,皮肤泛起诡异的黄色光泽。医生们束手无策,只能眼睁睁看着他吐出黑色的血块,在痛苦中死去。这种被称为"黄杰克"的恐怖疾病,即将在接下来的三个月里夺走费城十分之一的人口——超过五千人死于这场瘟疫,其中包括城市最优秀的医生们。美国开国元勋本杰明·拉什称之为"我所见过的最可怕的灾难"。
这就是黄热病,一种曾经让整个美洲大陆颤抖的古老瘟疫。它的名字来自于最典型的症状——患者皮肤因肝脏衰竭而呈现金黄色,仿佛被死神亲手染上了死亡的印记。在超过五百年的时间里,这种病毒夺走了数百万人的生命,摧毁了无数城市,让法国人放弃了巴拿马运河的梦想,甚至在某种程度上塑造了现代美洲的人口格局。

病毒的微观世界:子弹形状的死亡使者
黄热病病毒属于黄病毒科(Flaviviridae),这个名字来源于拉丁语"flavus",意为"黄色"。它是人类最早发现的病毒之一,也是第一个被证实由蚊子传播的人类病毒。在电子显微镜下,黄热病病毒呈现出一个完美的球形体,直径约40至50纳米,表面覆盖着细密的蛋白质棘突,像一个微小的、致命的刺猬。
病毒的核心是一段单链RNA基因组,长度约为11,000个核苷酸。这段简洁的遗传密码包含了制造下一代病毒所需的所有指令。病毒颗粒的最外层是由脂质和蛋白质组成的包膜,上面镶嵌着两种关键的糖蛋白:E蛋白(包膜蛋白)和M蛋白(膜蛋白)。E蛋白是病毒入侵细胞的钥匙,它能够识别并结合宿主细胞表面的特定受体,就像一把精密的钥匙插入了细胞的门锁。
当一只携带黄热病病毒的埃及伊蚊(Aedes aegypti)叮咬人类时,病毒随着蚊子的唾液进入人体。这个入侵过程极其隐秘而高效。蚊子的唾液中含有抗凝血剂和免疫抑制剂,这些物质在帮助蚊子吸血的同时,也为病毒的入侵铺平了道路。病毒首先感染的是皮肤中的树突状细胞——这些细胞是免疫系统的前线哨兵,本应负责识别并报告入侵者。然而,黄热病病毒却将这些哨兵变成了自己的特洛伊木马。
被感染的树突状细胞带着病毒移动到最近的淋巴结,这里是免疫系统集结军队的指挥中心。病毒在淋巴结中大量复制,感染更多的免疫细胞,然后通过淋巴系统和血液循环扩散到全身。这个过程通常需要三到六天的潜伏期,患者在此期间没有任何症状,却可能已经成为了病毒的传播源。

当症状开始出现时,往往以突然的高烧开场。体温可以迅速攀升至39到40摄氏度,伴随着剧烈的头痛、肌肉疼痛、恶心和呕吐。这个阶段被称为"中毒期",病毒正在全身肆虐。大约15%的患者会进入更危险的阶段——毒性期,这是黄热病最令人恐惧的特征开始显现的时候。
肝脏,这个人体最大的内脏器官,成为了黄热病病毒的主要攻击目标。病毒进入肝细胞后,开始了一场残酷的分子级屠杀。它利用肝细胞的蛋白质合成机器,大量复制自己的基因组,组装新的病毒颗粒。每一个被感染的肝细胞可以产生成千上万个新病毒,这些病毒破细胞而出,去感染更多的细胞。
然而,病毒的直接破坏只是肝脏损伤的一部分。更致命的是人体自身的免疫系统对感染的反应。细胞毒性T细胞——免疫系统的杀手细胞——会识别并攻击被感染的肝细胞,试图阻止病毒的扩散。在这场激烈的战斗中,大量肝细胞通过细胞凋亡(程序性细胞死亡)的方式死去。在严重的病例中,高达70%的肝细胞会在短时间内死亡或凋亡。
肝脏的毁灭:从中区坏死到金色死神
黄热病对肝脏的攻击呈现出一种独特而诡异的模式,这种模式在病理学上被称为"中区坏死"(midzonal necrosis)。肝脏的基本功能单位是肝小叶,呈六边形结构,血液从周边流向中央。正常情况下,肝细胞在小叶内均匀分布,承担着代谢、解毒、合成蛋白质等关键功能。
当黄热病病毒入侵时,肝小叶中区——位于周边和中央之间的区域——的肝细胞最先死亡。这种选择性的损伤模式至今仍是病理学之谜。一种理论认为,中区的肝细胞具有独特的代谢特征,使它们对病毒感染或免疫介导的损伤特别敏感。另一种理论则认为,病毒通过某种机制特异性地靶向了这个区域的细胞。

无论机制如何,中区坏死的结果是灾难性的。肝细胞大量死亡后,它们的位置被脂肪滴填充——这种现象被称为脂肪变性或脂肪肝。在显微镜下,死亡的肝细胞呈现为嗜酸性的小体,被称为"康希尔曼小体"(Councilman bodies),以美国病理学家威廉·托马斯·康希尔曼的名字命名。他在1890年首次描述了这种病理特征,成为黄热病诊断的重要标志。
康希尔曼小体实际上是正在凋亡的肝细胞残余。它们呈圆形或椭圆形,染色呈深红色,直径约10至20微米。每一个康希尔曼小体都代表着一个曾经活着的细胞,一个被病毒和免疫系统联手杀死的无辜受害者。在严重的黄热病病例中,肝小叶内可见大量康希尔曼小体,肝细胞的正常结构被彻底破坏。
肝脏功能的衰竭引发了一系列连锁反应。首先受到影响的是胆红素的代谢。正常情况下,肝脏会将红细胞分解产生的胆红素转化为可溶于水的形式,然后通过胆汁排出体外。当肝细胞大量死亡时,胆红素在血液中积累,渗透到皮肤和眼球的结膜中,使患者呈现出特征性的金黄色——这就是"黄热病"名称的由来。
更致命的是凝血因子的合成中断。肝脏负责生产大多数凝血蛋白,包括凝血酶原(因子II)、纤维蛋白原(因子I)以及因子V、VII、IX和X。当肝细胞死亡时,这些凝血因子的产量急剧下降。患者开始出现严重的出血倾向:牙龈出血、鼻出血、皮下淤血。最令人毛骨悚然的是所谓的"黑呕吐物"——患者呕吐出大量黑色的、类似咖啡渣的物质。这是胃出血后血液被胃酸消化的结果,是黄热病患者即将死亡的凶兆。

出血并不仅仅发生在消化道。在致命的病例中,患者可能出现脑出血、肺部出血、子宫出血,甚至从注射针孔处渗血不止。凝血系统的崩溃,加上病毒对血管内皮细胞的直接损伤,使黄热病成为一种可怕的出血热。患者可能在发病后七到十天内死于失血性休克、肝性脑病或多器官功能衰竭。
然而,即使在这种极端的情况下,人体仍在进行着绝望的抵抗。幸存者的免疫系统最终会战胜病毒。中和抗体在感染后一周左右开始出现,它们能够结合病毒颗粒,阻止其感染新的细胞。细胞毒性T细胞则继续清除被感染的细胞。如果患者能够熬过毒性期,他们通常会完全康复,并获得终身的免疫力。
美洲的噩梦:从奴隶船到废墟城市
黄热病的起源可以追溯到非洲的热带雨林。在那里,病毒在猴子和丛林蚊子之间循环传播,形成一个古老的生态系统。人类只是偶尔闯入这个循环的意外访客。然而,随着15世纪末大航海时代的开启,一切都改变了。
奴隶贸易是黄热病进入美洲的关键途径。欧洲的奴隶船从西非海岸装载着成千上万的非洲人,将他们运往新大陆的种植园。这些船只不仅运载着人类货物,还带来了隐藏在他们血液中的病毒,以及潜伏在水桶和船舱中的埃及伊蚊幼虫。这是一种致命的组合:病毒、媒介和易感人群,同时被运输到了一个全新的环境。
美洲的原住民对黄热病完全没有免疫力。在欧洲人到达之前,这片大陆从未有过这种病毒。当黄热病开始在加勒比海的岛屿上蔓延时,它造成的破坏是毁灭性的。巴巴多斯岛的第一次有记录的黄热病流行发生在1647年,几乎消灭了岛上的全部白人人口。据估计,在该世纪的下半叶,巴巴多斯每年有约10%的白人居民死于黄热病。
这种疾病的恐怖之处在于它对"新来者"的偏爱。从欧洲新到的移民、士兵和水手,对黄热病完全没有免疫力,死亡率极高。而在疫区长期生活的人,尤其是非洲后裔,可能因儿时的感染而获得了部分免疫力。这种差异加深了种族偏见,许多人错误地认为黑人对黄热病有天然的抵抗力。实际上,这只是免疫记忆的差异,而非种族特质。
1793年的费城大流行是黄热病在美国本土最惨烈的篇章之一。那个夏天,来自加勒比海的难民船带来了病毒和蚊子。费城当时是美国最大的城市,拥有约5万人口,也是新生美利坚合众国的临时首都。城市的卫生条件极差,街道上堆积着垃圾和污水,为蚊子的繁殖提供了理想的场所。
当疫情开始蔓延时,恐慌笼罩了整座城市。当时的医学理论认为黄热病是由"瘴气"——腐烂物质产生的有毒气体——引起的。没有人知道真正的罪魁祸首是一只小小的蚊子。城市精英们纷纷逃离,包括乔治·华盛顿总统和托马斯·杰斐逊国务卿。政府机构陷入瘫痪,费城几乎变成了一座鬼城。
留下来的居民面临着死亡的威胁。医院人满为患,医护人员大批感染死亡。那些能够逃走的人抛弃了患病的朋友和邻居,有些家庭甚至将病倒的成员赶到街上等死。尸体堆在路边,来不及埋葬。殡葬工人或病死或逃跑,市政府不得不雇佣囚犯来搬运尸体。
在这场灾难中,费城的非洲裔美国人社区展现出了非凡的勇气。在两位黑人领袖理查德·艾伦和艾比索尔·琼斯的带领下,黑人志愿者们承担起了护理病人和埋葬死者的工作。他们被当时的主流医学理论误导,相信黑人对黄热病免疫。结果,许多黑人志愿者也感染并死于黄热病。在这场疫情中,费城共有240名非洲裔美国人死亡,占该社区人口的十分之一以上。
1878年的密西西比河谷流行是北美历史上最严重的黄热病疫情。这场灾难始于新奥尔良,然后沿着密西西比河向北蔓延,波及田纳西州的孟菲斯、密西西比州的维克斯堡等城市。当年的气候条件特别有利于蚊子的繁殖:温和的冬天之后是一个漫长潮湿的春季,接着是炎热的夏季。
孟菲斯遭受的打击尤为惨重。这座拥有4万人口的城市在几个月内失去了5000多居民,另有约2.5万人逃往外地。那些留下来的市民中,死亡率高达70%。城市的基础设施完全崩溃,商店关闭,邮局停止服务,连掘墓人都病死或逃跑了。尸体被随意堆放在公墓中,有的家庭甚至将亲人的遗体扔进街道,让市政人员收走。
这场瘟疫改变了孟菲斯的命运。疫情过后,城市失去了特许状,被迫宣布破产。人口锐减,经济凋敝,孟菲斯用了几十年才恢复元气。然而,这场灾难也催生了现代公共卫生系统的诞生。疫情之后,联邦政府成立了国家卫生委员会,各州开始建立永久性的卫生部门。黄热病以一种残酷的方式,推动了美国公共卫生事业的进步。
法国人的葬礼:巴拿马运河的鲜血代价
1881年,法国人费迪南·德·雷赛布开始了他在巴拿马地峡的伟大梦想。这位曾经成功建造苏伊士运河的工程师,决心再造奇迹,打通大西洋和太平洋。然而,他没有预料到的是,黄热病和疟疾将成为这项工程最致命的敌人。
法国人在巴拿马的九年是一场持续的噩梦。每年,成千上万的工人从加勒比海岛屿、欧洲和亚洲被招募到巴拿马,投入到运河的挖掘工作中。他们住进简陋的棚屋,在潮湿闷热的丛林中劳作。没有人知道,在他们周围的水坑、水桶和废弃容器中,埃及伊蚊和按蚊正在大量繁殖。
死亡来得快速而无情。1884年,巴拿马运河公司的一名工程师在日记中写道:“昨天我们埋葬了十五个人,今天又有二十人倒下。医院里挤满了垂死的工人,医生们自己也在接连死去。这里不是一个建筑工地,而是一个墓地。”
据统计,在法国人经营巴拿马运河的九年中,约有2万至2.5万名工人死于疾病,其中大部分是黄热病和疟疾。医院永远人满为患,有时一张病床要挤两三个病人。那些幸存下来的人也常常终身带有后遗症:肝脏损伤、脾脏肿大、慢性贫血。
法国人对疾病的恐惧达到了极点。每当有人开始发烧,同事们就会本能地远离他。有些工人为了避免感染,选择睡在户外的树林里,结果反而更容易被蚊子叮咬。医院的工作人员大批辞职或病死,运河公司不得不以高薪从欧洲招募新的医生,但许多人到达后不久就病倒了。
1889年,巴拿马运河公司破产。德·雷赛布的梦想以失败告终,他自己也因为丑闻和财务崩溃而身败名裂。黄热病和疟疾不仅杀死了数万名工人,也摧毁了一项伟大的工程和一个人的声誉。这次失败深刻地教训了世界:在热带地区进行大规模工程,必须首先征服疾病。
一个古巴医生的孤独战斗
在黄热病肆虐美洲的几个世纪里,没有人知道它真正的原因。主流医学理论认为,这种疾病是由"瘴气"——腐烂有机物产生的有毒气体——引起的。有些医生则怀疑它与患者的接触有关,提出各种各样的隔离措施。然而,所有这些理论都没有触及真相。
1881年,一个名叫卡洛斯·芬莱的古巴医生在哈瓦那的科学会议上提出了一个革命性的假说。他声称,黄热病是由蚊子传播的。芬莱观察到,黄热病的流行总是与蚊子的活动季节吻合,而且在没有蚊子的地方,即使有病人也不会引发流行。他甚至指出了具体的蚊种:埃及伊蚊。
然而,芬莱的理论遭到了科学界的普遍嘲笑。他被讥讽为"疯子"和"怪人",他的论文被主流医学期刊拒绝发表。当时的医学权威们无法接受一个如此简单的生物——一只蚊子——能够传播如此致命的疾病。芬莱花了近二十年的时间试图证明自己的理论,设计了各种实验,却始终未能获得决定性的证据。
问题部分在于芬莱实验方法的缺陷。他让蚊子叮咬黄热病患者后,再叮咬健康志愿者。然而,他不知道的是,蚊子感染病毒后需要一段时间的外潜伏期——大约12天——才能具有传染性。芬莱的实验往往在蚊子刚刚吸食病人血液后就进行,此时病毒还没有在蚊子体内完成复制和迁移到唾液腺的过程。
1900年,美国陆军派遣了一个特别委员会前往古巴,调查在西班牙-美国战争中夺走更多士兵生命的黄热病。委员会由沃尔特·里德少校领导,成员包括詹姆斯·卡罗尔、阿里斯蒂德斯·阿格拉蒙特和杰西·拉扎尔。他们来到哈瓦那,开始系统地研究黄热病的传播方式。
里德和他的同事们首先排除了接触传播的理论。他们建造了一个密封的小屋,让志愿者在里面与黄热病患者的脏衣物、呕吐物和排泄物共同生活数周。没有一个人感染疾病。这个实验虽然在今天看来极其危险和不道德,却有力地证明了黄热病不是通过直接接触传播的。
然后,里德的团队开始测试芬莱的蚊子理论。他们让埃及伊蚊叮咬黄热病患者,等待一段时间后,再让这些蚊子叮咬健康志愿者。1900年8月,第一名志愿者——詹姆斯·卡罗尔本人——同意被叮咬。几天后,他出现了典型的黄热病症状,虽然最终康复,但经历了极其痛苦的病程。

最悲剧的是杰西·拉扎尔。这位年轻医生在实验中让蚊子叮咬自己,以验证蚊子传播理论。1900年9月,他感染了黄热病,一周后死于并发症。拉扎尔的牺牲证明了蚊子传播理论的真实性,也让他成为医学史上最令人尊敬的烈士之一。里德后来写道:“他是一个杰出的、勇敢的人,我为失去这样一位同事和朋友而深感悲痛。”
里德继续在古巴建立一个专门的实验营地——以拉扎尔的名字命名为"拉扎尔营"——进行更系统的实验。他们招募了西班牙移民作为志愿者,为每个人提供书面知情同意书,这被认为是医学史上第一次正式使用知情同意程序。志愿者被告知实验的风险,并被支付100美元作为参与报酬(在当时是一笔可观的数目)。如果感染黄热病,额外的100美元将作为补偿;如果死亡,这笔钱将支付给家属。
这些实验最终证实了芬莱的理论:黄热病确实是由埃及伊蚊传播的。芬莱在被忽视二十年后,终于得到了应有的认可。然而,他的理论被证实的同时,也开启了一场大规模的灭蚊运动,将彻底改变美洲的公共卫生格局。
威廉·戈加斯的灭蚊战争
证明了蚊子传播黄热病之后,下一步就是消灭蚊子。威廉·克劳福德·戈加斯,一位曾在古巴服役的美国陆军医生,成为了这场灭蚊战争的统帅。
戈加斯在哈瓦那开始了他的第一个实验。他组织了一支"蚊子旅",系统地清除城市中的蚊子繁殖地:排干积水、清理垃圾、给水桶加盖、在水面喷洒煤油。煤油形成的薄膜能够窒息蚊子幼虫,这是当时最有效的杀幼虫方法之一。
戈加斯的策略非常成功。在短短几个月内,哈瓦那的黄热病病例急剧下降。1901年,这座城市只报告了18例黄热病,而在此前的年份,每年的病例数以千计。这次成功使戈加斯声名鹊起,也让他获得了领导巴拿马运河卫生工作的机会。
1904年,美国接管了法国人失败的巴拿马运河项目。戈加斯被任命为首席卫生官,负责保护工人的健康。然而,他面临的是一个巨大的挑战:巴拿马地峡是黄热病和疟疾的天堂,热带雨林、沼泽和河流为蚊子提供了无限的繁殖场所。
戈加斯的灭蚊行动规模空前。他雇佣了数千名工人,配备专门的装备,系统地搜索和消灭每一个可能的蚊子繁殖地。他们填平沼泽、清理河道、给建筑物安装纱窗、在居民区喷洒杀虫剂。整个运河区被划分为若干卫生区,每个区都有专门的卫生官员负责监测和灭蚊。
这场"卫生战争"耗资巨大,每年花费数百万美元。运河管理部门曾一度质疑这种巨额开支的必要性,但戈加斯坚持他的策略。他告诉质疑者:“你们可以现在花钱灭蚊,或者将来花更多的钱埋葬工人。”
历史证明了戈加斯是正确的。到1906年,黄热病在巴拿马运河区基本被消灭。最后一例黄热病报告出现在1906年5月,此后,这种曾经夺走数万人生命的疾病在运河区销声匿迹。疟疾的发病率也大幅下降,虽然未能完全消灭。
戈加斯的成功使巴拿马运河的建成成为可能。从1904年到1914年,约有5.6万名工人在运河区工作,因疾病死亡的人数不到6000人。相比之下,法国人时期的死亡率是其十倍以上。戈加斯后来写道:“我们在巴拿马证明了,黄热病是可以被控制的。这不是医学的胜利,而是公共卫生的胜利。”
疫苗的诞生:马克斯·泰勒的诺贝尔之路
虽然灭蚊运动成功控制了黄热病的传播,但科学家们仍在寻找更直接的预防方法:一种能够提供持久免疫力的疫苗。1927年,研究人员首次证实黄热病是由一种过滤性病毒引起的,这为疫苗研发铺平了道路。
疫苗研发的突破来自洛克菲勒基金会的一位南非裔病毒学家:马克斯·泰勒。泰勒在1928年开始研究黄热病病毒,他首先发现了一种让病毒在小白鼠体内繁殖的方法。通过反复将病毒从一个宿主转移到另一个宿主,泰勒观察到病毒的毒力逐渐减弱,同时保留其激发免疫反应的能力。
这是一种古老的技术——减毒活疫苗——但泰勒将其应用到了一个全新的领域。他使用了一种名为"阿西比"的黄热病病毒株,这株病毒最初是从一位加纳患者身上分离得到的。泰勒将病毒连续接种到小白鼠的大脑中,每接种一次,病毒对人类的毒性就降低一点。
经过一系列复杂的传代实验——从小白鼠到鸡胚组织培养——泰勒最终获得了被称为"17D"的减毒病毒株。这个名称来源于实验记录:病毒在鸡胚组织中传代了第17次,D代表"减毒"(derived)。17D株能够感染人类并激发强烈的免疫反应,但几乎不会引起疾病症状。
1937年,17D疫苗开始大规模生产和使用。临床试验显示,它能够提供高度有效的保护,而且副作用极少。这是人类历史上第一个成功的黄热病疫苗,也是第一个能够大规模生产的病毒疫苗之一。
泰勒的成就获得了广泛认可。1951年,他被授予诺贝尔生理学或医学奖,成为唯一一位因研发病毒疫苗而获得诺贝尔奖的科学家。在颁奖典礼上,泰勒谦逊地表示,这个奖项属于所有为征服黄热病而付出努力的人,包括那些献出生命的先驱者。
17D疫苗至今仍在使用,被认为是人类发明的最安全、最有效的疫苗之一。单次接种能够提供终身免疫力,全球已有数亿人接种了这种疫苗。然而,在疫苗研发的早期,也曾发生过悲剧。1942年,一批被污染的黄热病疫苗导致约30万美军士兵感染乙肝病毒,数十人死亡。这次事件促使疫苗生产过程的彻底改革,也标志着现代疫苗质量控制标准的建立。
现代的阴影:丛林中的不死死神
黄热病从未真正消失。虽然城市黄热病——由埃及伊蚊在人群中传播——在大规模疫苗接种和灭蚊运动的控制下已经罕见,但丛林黄热病仍在南美洲和非洲的热带雨林中循环。病毒在猴子和丛林蚊子之间传播,偶尔感染进入森林的人类。
2016年至2018年,巴西经历了几十年来最严重的黄热病疫情。病毒从传统的丛林地区向东南方向蔓延,抵达了人口稠密的圣保罗、里约热内卢和米纳斯吉拉斯州。在不到两年的时间里,巴西报告了近2000例确诊黄热病病例,数百人死亡。
更令人担忧的是,疫情首先表现为猴子的大量死亡。在巴西东南部的森林中,数千只吼猴和其他灵长类动物被发现死亡。当地居民一度将这些动物死亡归咎于某种神秘力量,甚至有人开始杀死猴子,以为这样可以阻止疾病的传播。实际上,猴子的死亡是黄热病病毒活跃的早期预警信号。
这次疫情暴露了现代公共卫生体系的脆弱性。虽然黄热病疫苗已经存在了近一个世纪,但许多高风险地区的居民从未接种。疫苗的冷链运输和储存需要完善的医疗基础设施,而偏远地区的居民往往难以获得接种服务。
另一个令人担忧的趋势是气候变化可能扩大黄热病的传播范围。随着全球气温升高,埃及伊蚊的活动范围正在向更高纬度和更高海拔地区扩展。原本被认为"太冷"而不适合蚊子生存的地区,正在逐渐变得适宜。这意味着黄热病可能在未来的某个时刻,重新出现在已经几十年没有病例的地区。
世界卫生组织估计,全球每年仍有约8.4万至17万例黄热病病例,导致2.9万至6万人死亡。绝大多数病例发生在非洲,那里有34个国家被认为是黄热病流行区。2016年,安哥拉和刚果民主共和国爆发的黄热病疫情导致数百人死亡,耗尽了全球的黄热病疫苗储备。
面对这些挑战,国际社会发起了"消除黄热病流行"战略。这个雄心勃勃的计划旨在通过大规模疫苗接种运动,保护超过10亿生活在高风险地区的人口。从2017年到2026年,超过30个国家计划为高风险人群提供常规免疫和大规模接种活动。
黄热病的故事是人类与传染病漫长斗争的缩影。从费城的废弃街道到巴拿马的丛林,从一个被嘲笑的古巴医生到诺贝尔奖的领奖台,人类花了几个世纪的时间才真正理解并部分征服了这种古老的杀手。然而,病毒从未真正投降。它潜伏在热带雨林的阴影中,等待着下一个机会。只要我们松懈警惕,这个金色的死神就会重新从蚊子的翅膀下升起,再次书写血腥的历史。
参考资料
-
Monath TP, Barrett AD. Pathogenesis and pathophysiology of yellow fever. Adv Virus Res. 2003;60:343-395.
-
Theiler M, Smith HH. The Use of Yellow Fever Virus Modified by in Vitro Cultivation for Human Immunization. J Exp Med. 1937;65(6):787-800.
-
Reed W, Carroll J, Agramonte A, Lazear JW. The etiology of yellow fever: a preliminary note. Philad Med J. 1900;6:790-796.
-
Staples JE, Monath TP. Yellow fever: 100 years of discovery. JAMA. 2008;300(8):960-962.
-
Barrett AD, Higgs S. Yellow fever: a disease that has yet to be conquered. Annu Rev Entomol. 2007;52:209-229.
-
Quaresma JA, Barros VL, Pagliari C, et al. Revisiting the liver in human yellow fever: virus-induced apoptosis in hepatocytes associated with TGF-beta, TNF-alpha and NK cells infiltrates create severe disease. J Med Virol. 2006;78(11):1430-1437.
-
Paules CI, Fauci AS. Yellow Fever — Once Again on the Radar Screen in the Americas. N Engl J Med. 2017;376(15):1397-1399.
-
Frierson JG. The yellow fever vaccine: a history. Yale J Biol Med. 2010;83(2):77-85.
-
World Health Organization. Yellow fever fact sheet. WHO, 2024.
-
Centers for Disease Control and Prevention. Yellow fever: Transmission. CDC, 2024.